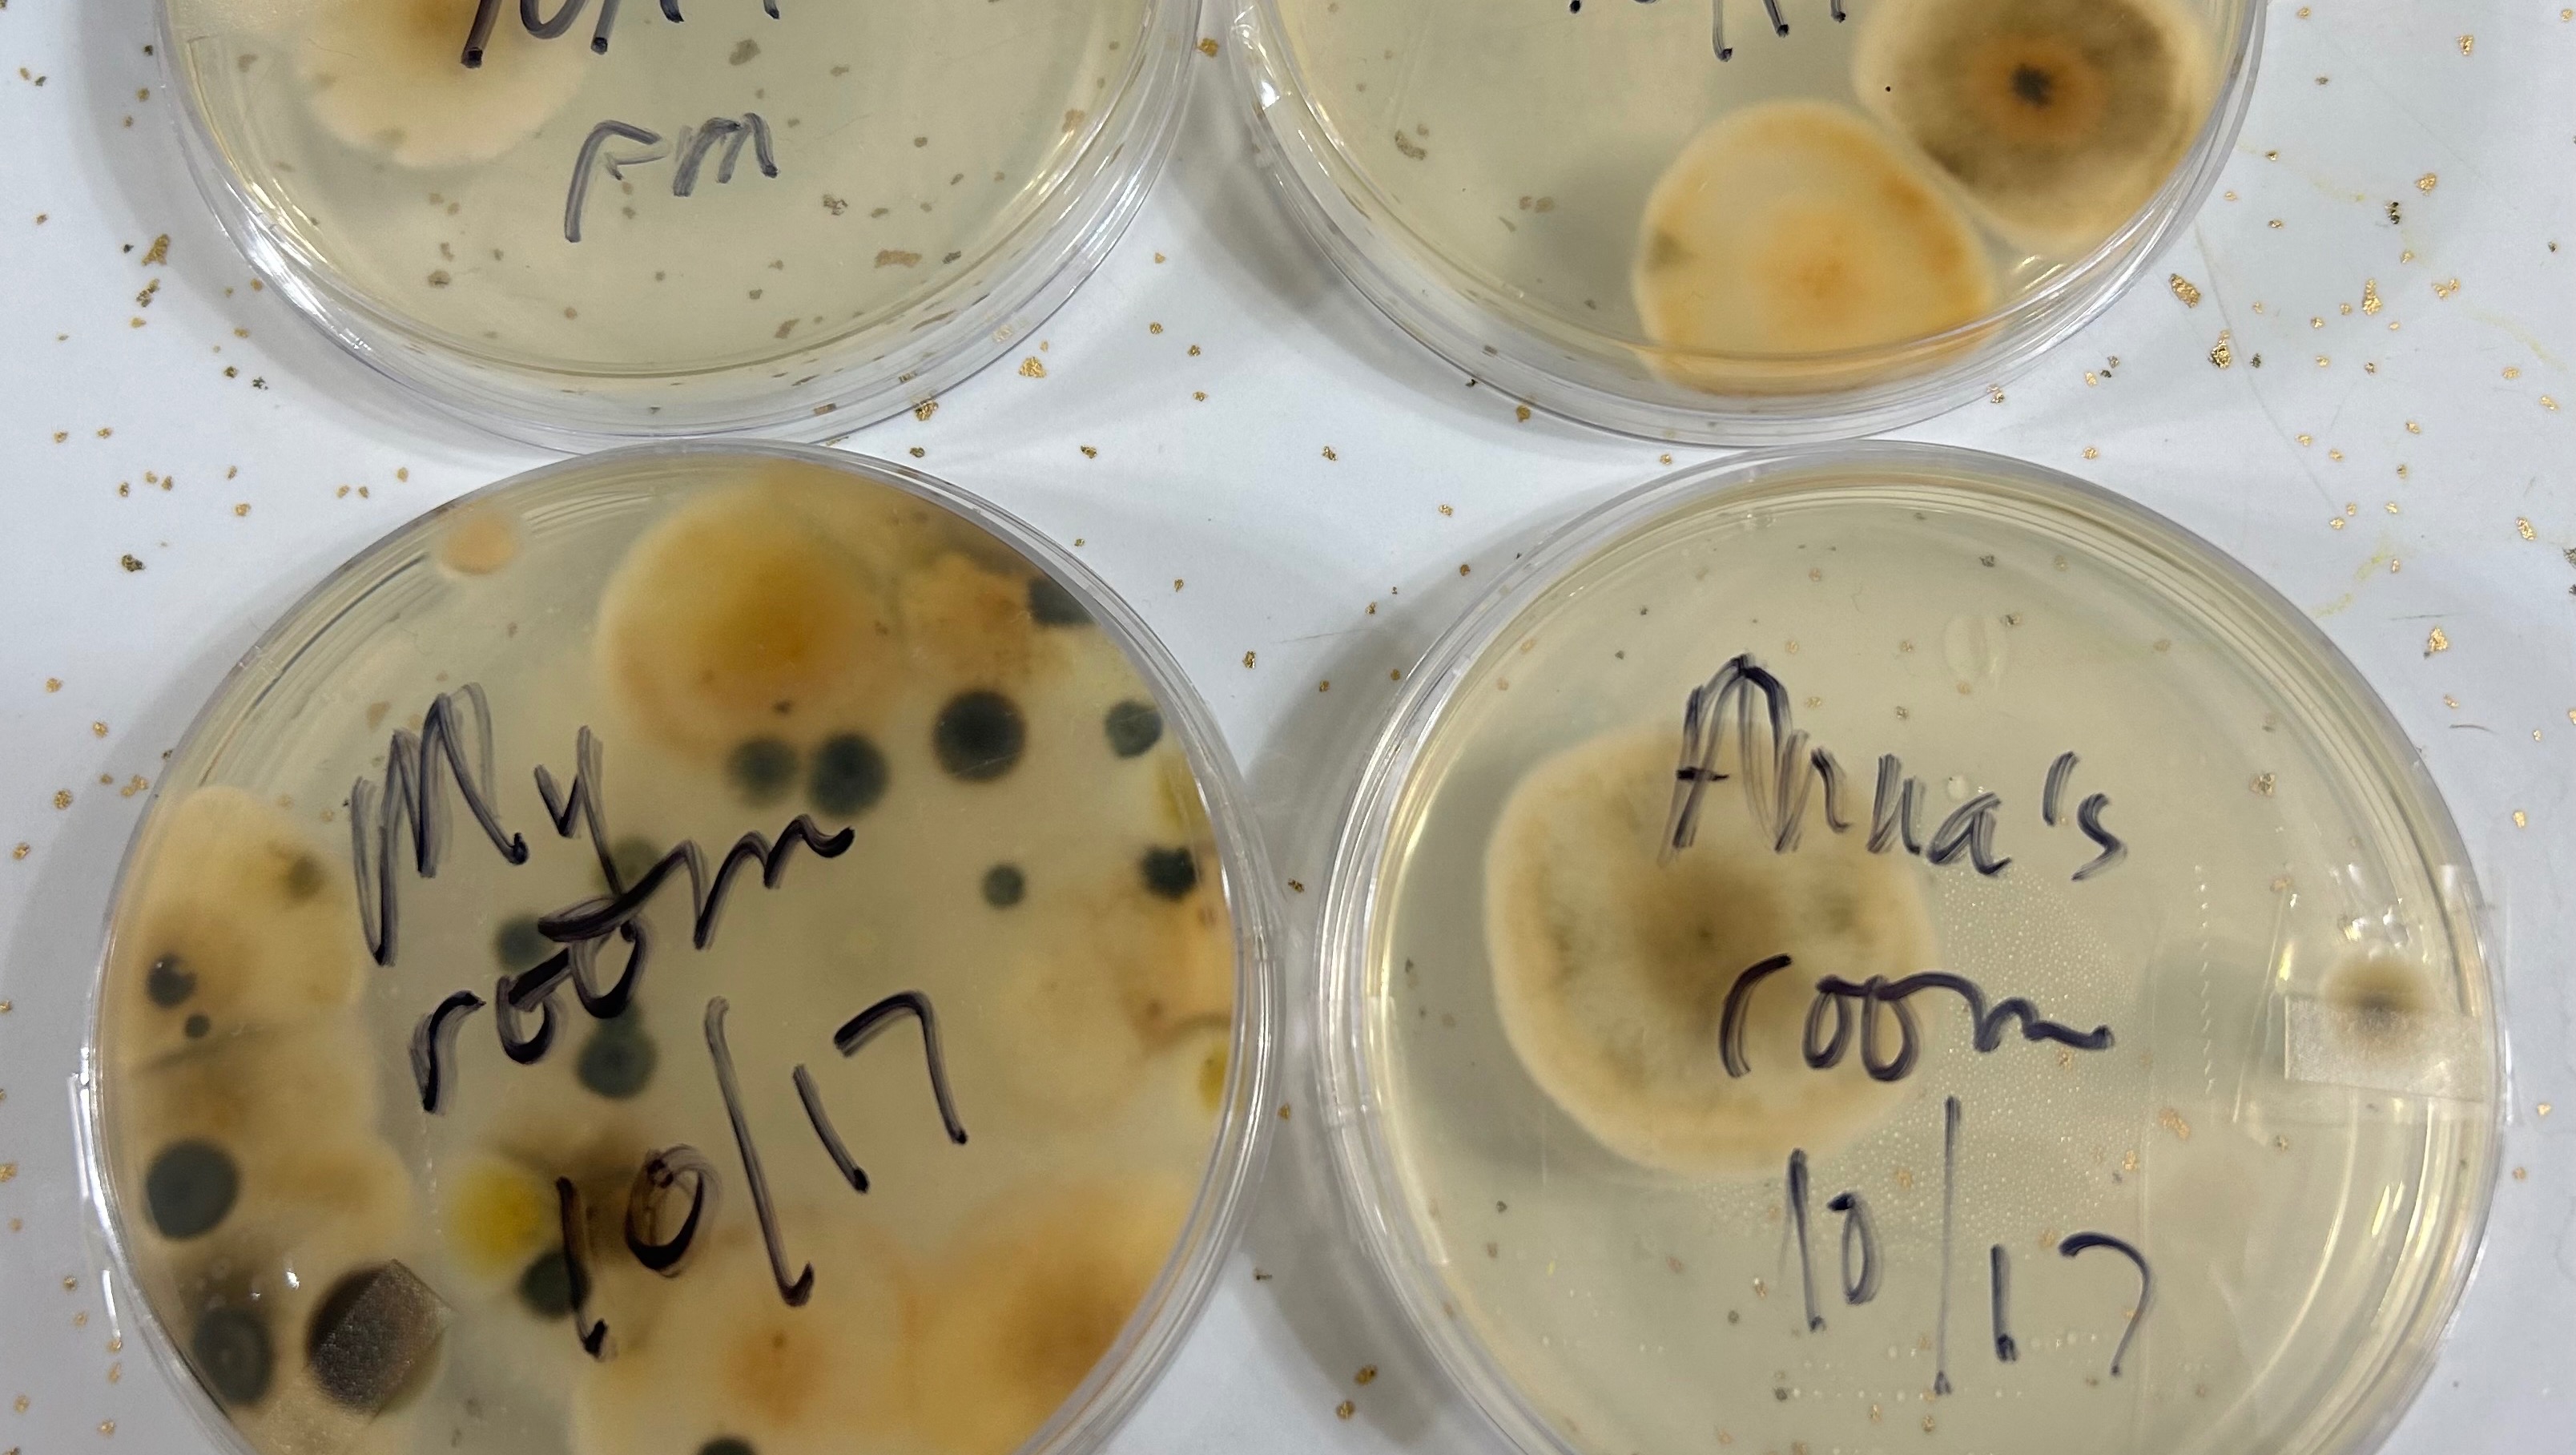

- L
- M
*(Photos and diagnosis info at end of description of illness)*
Many are unaware that Shannon has been grappling with serious chronic health issues for quite some time because she has put on a 'brave face' for Anna, and when in public or on social media. She was also trying to appear strong so she could continue in her sales job and keep her clients confidant in her abilities, but her illness has been so severe that it has been impossible for her to keep up. She has not been able to work very much due to extreme pain and fatigue, and that has added more stress, which has made it even harder for her to get well.
Being misdiagnosed with Chronic Fatigue Syndrome and Fibromyalgia for years, Shannon said she knew there had to be an actual cause for her failing condition. Using her background as a Vet Tech, she took the initiative to learn more on her own and find answers. She sent in her own Lyme and Coinfection test, and with those positive results, she continued researching and testing herself (as well as testing through clinics/hospitals) to obtain a complete diagnosis - which includes chronic Lyme Disease, along with several other pathogenic coinfections, and a failing immune system that led to a huge toxic burden, several vitamin/antioxidant deficiencies because of food malabsorption from poor gut health, anemia and thrombocytopenia (low platelets - which causes extensive bruising all over her body, petechial hemorrhaging under her skin, and she runs the risk of internal hemorrhaging). In the last year she has been hospitalized twice and had 3 blood transfusions, plus several IV therapies due to dehydration, and has been unable to keep working because of all of the complications that encompass her entire body and the myriad of symptoms that comes with these complex diseases.
With the support of her provider at West River Health Services and 2 separate LLMDs (Lyme Literate Medical Doctors) she has been undergoing treatment and is slowly getting a bit better, but it takes a lot of time to remove the toxins like black mold, heavy metals, plus the disease-causing pathogens, and also working to regain a healthy immune system. She has found that trying to rid her body of the toxins and pathogens too fast can cause unbearable pain, so there is no 'quick fix.' She has improved, from not being able to get out of bed or work at all from the pain and fatigue, to now being able to do some minimal activities and attend Anna's events. She said she does not have full good days yet, but is hopeful they are coming.
With her income much less and her expenses doubling because of the medical bills, and then finding black mold in their home, she has exhausted her credit trying to stay afloat as a single mom with a chronic illness that people can't 'see.' The Stachybotrys mold not only added to her immune system malfunction, but also meant more expenses because their home was making her incredibly sick and they needed to move to an apartment. She had already known the house was affecting her, but was afraid to take on more expense because of lack of funds and an inability to earn a living like she had before when she was healthy. However, once school ended last spring and Anna was now in the house all day, she started to notice problems with Anna's health, including hair loss like Shannon had. The fear of Anna becoming ill pushed her to get an apartment because she said she would not allow Anna to suffer from any of what she had been going through. They still live in the apartment now until the basement of their home is finished and *more importantly* her immune system is strong enough to live there (mycotoxins are smaller than mold spores and can be on every surface, in every crack, crevice and porous item, and can still affect an immunocompromised person even if remediation is done. Think of a cancer patient undergoing chemotherapy, their bodies cannot fight what can be 'normal' toxins for others).
Shannon has said she is embarrassed to have her financial struggle be known, but is out of options for help. She is starting a 'quieter' job in the near future, and she is hoping that will enable her to earn an income, and also be easier for her to do with the anemia and inflammation/pain she experiences. Unfortunately, the length of time that she has not been able to work has just been to great and the debt is too large.
We ask that you pray for Shannon and Anna and help them if you are able, and please feel free to share this!

Organizer and beneficiary
Shannon LeFebre
Beneficiary

